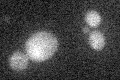
YBR158W
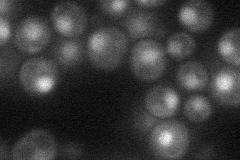
YBR158W
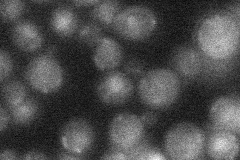
YBR158W

View description
Protein required for daughter cell separation, multiple mitotic checkpoints, and chromosome stability; contains 12 degenerate leucine-rich repeat motifs; expression is induced by the Mitotic Exit Network (MEN)
Localization:
Intensity:
Fold change:
Significance:
-
C’ GFP library in SD
cytosol19.46 -
N' NOP1pr-GFP in SD
nucleus24.0109 -
N' TEF2pr-mCherry in SD

below threshold5.20857 -
N' NATIVEpr-GFP in SD
punctate,nucleus22.7749 -
N' TEF2pr-VC and Cyto-VN in SD

#N/A0 -
C’ GFP library in SD+DTT

cytosol16.750.86No -
C’ GFP library in SD+H2O2

cytosol17.60.9No -
C’ GFP library in Starvation Media

cytosol15.320.78No -
C’ GFP library on the background of Pup2-DaMP

cytosol -
C’ GFP library on the background of CCT mutant

cytosol19.96961.02589No
